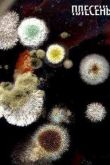

Не хлебом единым (2005)

Страна: Россия
Жанр: Драма, Русские
Продолжительность: 112 мин.
Качество: WEBDL
Она увлекается идеей Лопаткина и влюбляется в него, оставляя мужа. Он хотел быть полезным своей Родине, своему народу. Он был готов отдать жизнь ради своей идеи, она отдала ему свою жизнь, любовь и веру. Генерал мстит по-советски - не давая сопернику продвигать его изобретение...

 План А (2021)
План А (2021)
 Гензель и Гретель (2012)
Гензель и Гретель (2012)
 Тик-герой (1994) 1-3 сезон
Тик-герой (1994) 1-3 сезон
 Японская свежая выпечка (2004)
Японская свежая выпечка (2004)
Плесень (2008)
Плесень (2008)
 Король Конан (2024)
Король Конан (2024) Этерна (2025)
Этерна (2025)



































